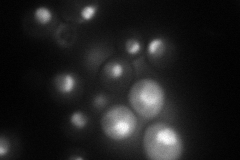
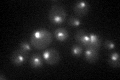

View description
Essential protein involved in rRNA processing and ribosome biogenesis
Localization:
Intensity:
Fold change:
Significance:
-
C’ GFP library in SD

nucleus80.75 -
N' NOP1pr-GFP in SD
nucleolus60.1929 -
N' TEF2pr-mCherry in SD

nucleus,nucleolus40.4272 -
N' NATIVEpr-GFP in SD

nucleus58.9589 -
N' TEF2pr-VC and Cyto-VN in SD

nucleolus33.5314 -
C’ GFP library in SD+DTT

nucleus64.830.8No -
C’ GFP library in SD+H2O2

punctateN/AN/ANo -
C’ GFP library in Starvation Media
punctateN/AN/AYes -
C’ GFP library on the background of Pup2-DaMP

nucleus -
C’ GFP library on the background of CCT mutant

nucleus70.68370.875278No
